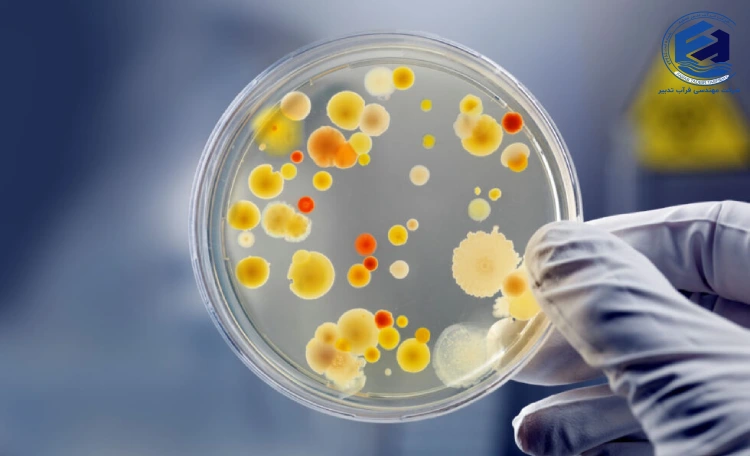
پارامترهای موثر بر رشد باکتری_ها در تصفیه فاضلاب

پارامترهای موثر بر رشد باکتریها در تصفیه فاضلاب از اهمیت ویژهای در بهبود عملکرد فرآیندهای تصفیه برخوردار هستند. این میکروارگانیسمها در تصفیه فاضلاب بهعنوان عوامل اصلی تجزیه آلایندهها در فرآیندهای هوازی و بیهوازی عمل میکنند و به سادهسازی ترکیبات پیچیده آلایندهها کمک مینمایند. باکتریها نه تنها در کاهش آلایندهها و تثبیت محصولات جانبی موثرند، بلکه در حذف مواد مغذی و تجزیه لجن نیز نقش اساسی ایفا میکنند.
برای دستیابی به بالاترین سطح کارایی در تصفیه فاضلاب، شناخت و کنترل پارامترهای موثر بر رشد باکتریها در تصفیه فاضلاب تاثیر دارند، امری ضروری است. پارامترهایی مانند دما، pH، دسترسی به مواد مغذی همچون کربن، نیتروژن و فسفر، میزان اکسیژن محلول و مواد آلی از جمله عواملی هستند که مستقیماً بر فعالیت و تکثیر این میکروارگانیسمها تاثیر میگذارند. مدیریت صحیح این پارامترها به بهبود فرآیند تصفیه و افزایش راندمان کمک خواهد کرد. فراب تدبیر در این مقاله به بررسی تاثیر هر یک از این عوامل بر رشد باکتریها در تصفیه فاضلاب پرداخته و اهمیت آنها را در کارایی سیستم تصفیه فاضلاب توضیح خواهد داد.
پارامترهای موثر بر رشد باکتریها در تصفیه فاضلاب
دما: دما تأثیر زیادی بر رشد باکتریها دارد. دمای مناسب باعث افزایش فعالیت متابولیک و سرعت رشد میشود، در حالی که دمای خیلی بالا یا پایین میتواند از تکثیر باکتریها جلوگیری کند یا آسیب به سلولهای آنها وارد کند.
:pH یکی از مهمترین پارامترها برای رشد و تکثیر میکروارگانیسمهای فاضلاب، سطح pH است. pH تأثیر زیادی بر روند تصفیه فاضلاب دارد، زیرا میتواند سرعت و کارایی فعالیت باکتریها را تحت تاثیر قرار دهد. در شرایط بهینه، یعنی در pH نزدیک به ۷ (بازه خنثی)، میکروارگانیسمها به بهترین نحو رشد و تکثیر مییابند. تغییرات جزئی در این محدوده میتوانند تاثیرات منفی بر فرآیند تصفیه بگذارند.
کاهش pH به زیر حد نرمال (حدود ۷) میتواند باعث کاهش فعالیت آنزیمی باکتریها شود و همچنین باعث توقف فرآیندهای مهم مانند نیتریفیکاسیون و تشکیل لخته گردد. در این شرایط، سولفید هیدروژن ممکن است به مقدار زیاد تولید شود که موجب بروز مشکلات بهداشتی و زیستمحیطی میشود. از سوی دیگر، افزایش pH بالاتر از حد مطلوب نیز میتواند موجب کاهش فعالیت آنزیمی و توقف فرآیندهای مهم تصفیه شود. در این حالت، افزایش تولید آمونیاک در فاضلابها بهوجود میآید که برای محیط زیست و فرآیند تصفیه خطرناک است.
مواد مغذی: کربن، نیتروژن و فسفر برای رشد باکتریها ضروری هستند. کمبود یا عدم تعادل این مواد میتواند رشد باکتریها را محدود کند، در حالی که مقادیر زیاد ممکن است باعث رشد کنترلنشده شوند.
اکسیژن محلول: سطح اکسیژن کافی برای فعالیت باکتریهای هوازی ضروری است. کمبود اکسیژن میتواند فرآیندهای متابولیکی را کاهش دهد و به تولید محصولات جانبی ناخواسته منجر شود.
میزان مواد آلی: مواد آلی منبع اصلی غذایی برای باکتریها هستند. غلظت زیاد مواد آلی میتواند رشد باکتریها را تقویت کند، اما در صورت بیش از حد بودن، میتواند باعث کاهش اکسیژن و ایجاد محصولات جانبی نامطلوب شود.
زمان ماند هیدرولیکی: مدت زمان تماس باکتریها با آلایندهها بر کارایی تصفیه تأثیر میگذارد. زمان ماند ناکافی میتواند مانع از تجزیه موثر مواد آلی شود.
فلزات سنگین یا مواد شیمیایی: وجود فلزات سنگین و سموم میتواند فعالیت باکتریها را کاهش دهد و فرآیندهای متابولیکی لازم برای تصفیه را مختل کند.
تأثیر رشد باکتریها در فرآیند تصفیه فاضلاب
رشد باکتریها در تصفیه فاضلاب به عنوان یکی از عوامل اصلی در کاهش آلایندهها و بهبود کیفیت پسابها نقش حیاتی دارد. مواد آلاینده موجود در فاضلابهای صنعتی و خانگی با ویژگیهای مختلفی که دارند، بهراحتی از طریق فرآیندهای بیولوژیکی تجزیه میشوند. باکتریها و میکروارگانیسمها قادرند مواد آلی موجود در فاضلاب را تجزیه کرده و با این کار، کیفیت پساب را بهبود بخشند. به عبارت دیگر، رشد بیشتر این باکتریها در فاضلاب میتواند فرآیند تصفیه را با سرعت و کارایی بالاتر انجام دهد، که این موضوع منجر به کاهش زمان و هزینههای تصفیه خواهد شد.
اما رشد بیش از حد باکتریها در تصفیهخانهها نیز ممکن است مشکلاتی ایجاد کند. افزایش جمعیت میکروارگانیسمها میتواند به تولید بیشتر لجن منجر شود که این خود هزینههای اضافی در مراحل بعدی تصفیه مانند آبگیری و دفع لجن به همراه دارد. بنابراین، لازم است که مقدار رشد باکتریها در حدی مناسب و کنترلشده باشد تا از بروز مشکلات جانبی جلوگیری شود.
سخن پایانی
رشد بهینه باکتریها و مدیریت دقیق پارامترهای موثر بر آنها نقش حیاتی در فرآیند تصفیه فاضلاب دارد. با توجه به اهمیت این عوامل، انتخاب سیستمهای تصفیه فاضلاب مناسب و کنترل شرایط محیطی میتواند به بهبود عملکرد و کارایی این فرآیند کمک کند. شرکت فرآب تدبیر با ارائه خدمات تخصصی تصفیه فاضلاب و پکیجهای تصفیه به صورت حرفهای و مطابق با استانداردهای روز دنیا، قادر است راهحلهای مناسب و مقرون بهصرفهای را برای بهبود کیفیت آب و فاضلاب به شما عزیزان ارائه دهد.